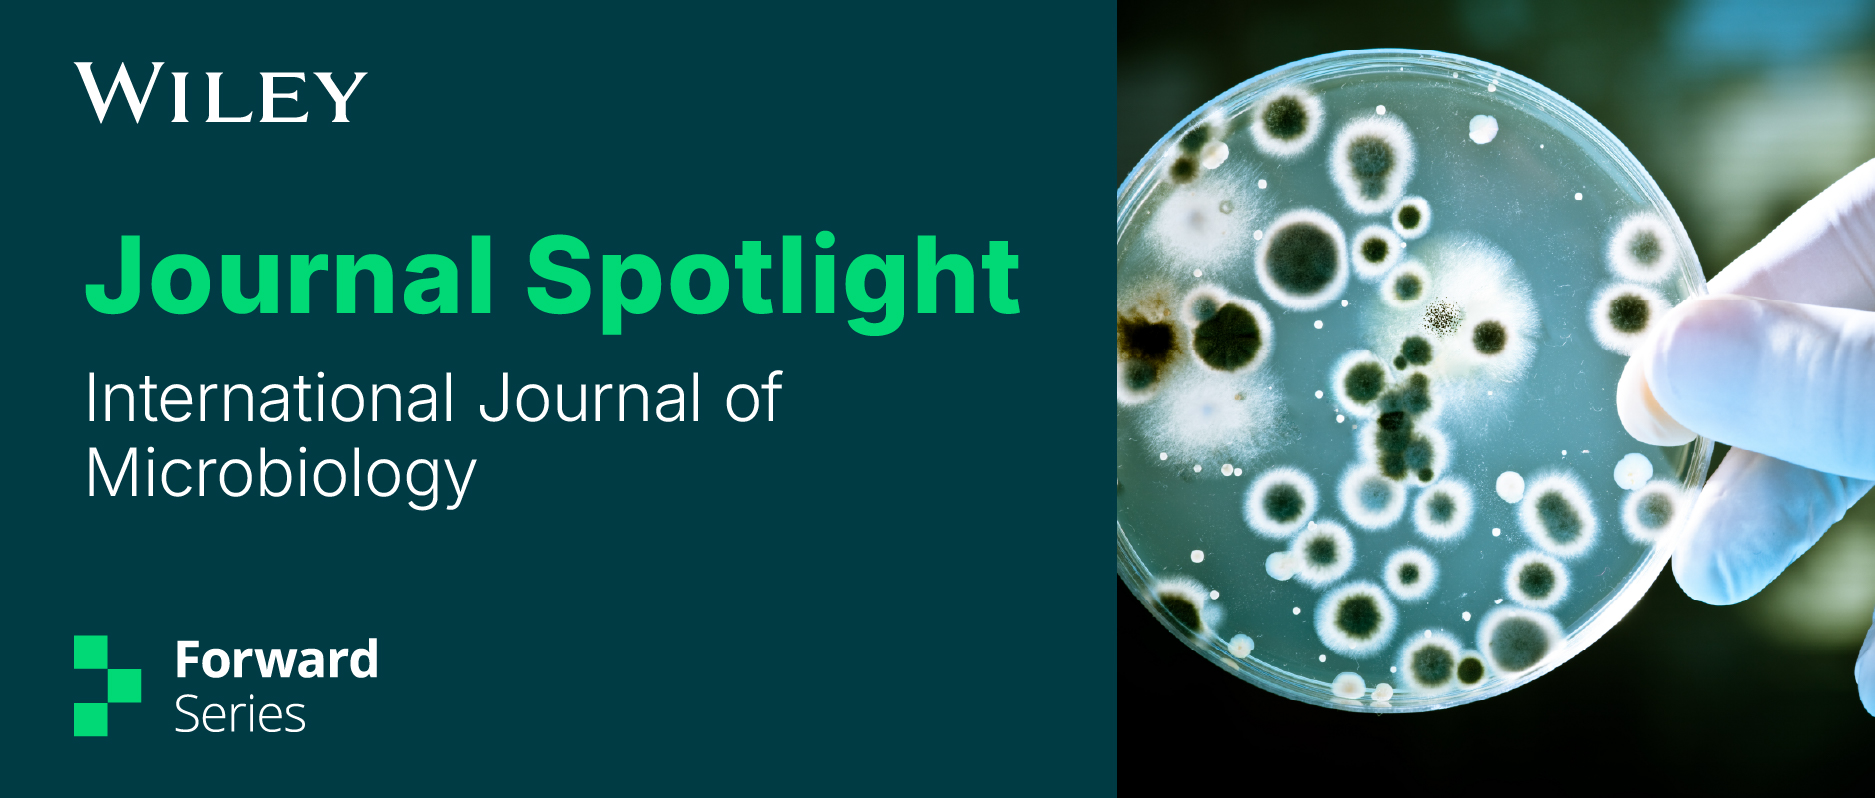
_journal-spotlight-wechat-banner_ijm.jpg

|
International Journal of Microbiology 是一本开放获取期刊,发表关于微生物及其与宿主和环境相互作用的研究论文。本刊涵盖所有微生物,包括细菌、真菌、病毒、古菌和原生动物。作为 Wiley全新推出的Forward Series的一部分,International Journal of Microbiology 期刊在维护科研诚信的同时采用了新的工作流程和程序,以提供高效、及时的出版体验。作者将获得切实可行的支持,以尽可能扩大其研究成果的触及范围和可见度。
2025年,International Journal of Microbiology 获得了最新的中国科学院期刊分区及最新影响因子等数据,结合期刊的最新出版指标,小编带您一起走近这本期刊,深入了解期刊的各方面信息。
期刊目标与范围
International Journal of Microbiology 是一本同行评审的开放获取期刊,发表关于微生物及其与宿主和环境相互作用的原创研究论文和综述文章。期刊涵盖所有微生物,包括细菌、真菌、病毒、古菌和原生动物,接收范围包括基础科学研究,以及医学和应用研究。
期刊主页:https://onlinelibrary.wiley.com/journal/8472
期刊指标、分区和数据库收录
最新关键指标(时间长度为中位数)
投稿至一审编辑决定:25天
从接受到发表时间:28天
期刊影响因子:3.2
CiteScore:6.7
期刊引文指标:0.69
文章处理费:1150美元
平均接受率(包含初筛和未送审拒稿):24%
WOS分区
本刊在最新发布的JCR分区MICROBIOLOGY(微生物学)类别中位于Q2区(76/163)。


中国科学院分区(2025年)
大类及分区
生物学3区
小类及分区
微生物学3区
自引率
自引率约为1%。
发文量与作者分布
期刊近五年发文量:391篇
作者分布:
作者主要来自中国、埃塞俄比亚、伊朗、南非和巴西等国家和地区,其中中国学者近5年发文占比约为5.115%。
主要接收文章类型
Research articles 研究论文
Reviews 综述
数据库收录情况
International Journal of Microbiology 被多个数据库收录,包括以下5个:
Web of Science核心合集(ESCI)
SCOPUS (Elsevier)
Pubmed
CAS: Chemical Abstracts Service (ACS)
CNKI Scholar
编委信息
International Journal of Microbiology 的主编是美国佛罗里达海湾海岸大学的Hidetoshi Urakawa教授。本刊拥有一支国际化高水平的学术编辑团队,其中大部分来自美国、中国、意大利、印度、巴西等国家和地区。
正在征稿的特刊
1.Thematic Collection: Waking up on Climate Change: Measuring Impact, Focusing Efforts and Building Futures
专题合集:气候变化觉醒:衡量影响、聚焦行动、构筑未来
投稿截止日期: 2026年3月31日
客座主编:Hidetoshi Urakawa,佛罗里达海湾海岸大学,佛罗里达州,美国
了解更多特刊详情:https://onlinelibrary.wiley.com/doi/toc/10.1155/8472.si.900031
2.Opportunistic Pathogens & ESKAPE Organisms, and Antimicrobial Resistance
机会性病原体与ESKAPE病原菌的感染及抗菌药物耐药性
投稿截止日期: 2026年4月13日
客座主编:Divakar Sharma,Graphic Era University, Dehradun, 印度
客座编辑:
Sandeep Sharma,拉夫里科技大学, Phagwāra, 印度
Shweta Negi, Wiley, 印度
了解更多特刊详情:https://onlinelibrary.wiley.com/doi/toc/10.1155/8472.SI-2025-000656
3.Plant-Biotic Interactions Special Collection: Mechanisms of Plant-Microbe Communication and Nutrient Exchange
植物-生物体相互作用专题合集:植物-微生物通讯与营养物质交换机制
投稿截止日期: 2026年6月30日
客座主编:Hidetoshi Urakawa,佛罗里达海湾海岸大学,佛罗里达州,美国
了解更多特刊详情:https://onlinelibrary.wiley.com/doi/toc/10.1155/8472.SI-2025-000723
我们将继续与作者、编辑、审稿人群体紧密合作,确保达到高质量标准。希望作者继续挖掘我们的期刊组合,并将其作为其研究成果的发表平台。
在 Wiley Online Library 上高效出版的开放获取期刊,提供透明的论文级别指标、便捷的社交分享选项、高水平的编辑支持(包括明确的编辑政策和编辑委员会)。期刊作者通过知识共享署名许可保留版权,符合开放获取要求和基金资助要求。
丨关于Forward 系列期刊
Forward系列期刊是Wiley 旗下OA(开放获取)期刊品牌之一,包含200多种基于可靠科学的期刊,提供快速精简的发表流程,注重学术严谨性和科研诚信,助力青年学者提升科研影响力。

Archiver|手机版|科学网 ( 京ICP备07017567号-12 )
GMT+8, 2026-4-4 05:59
Powered by ScienceNet.cn
Copyright © 2007- 中国科学报社